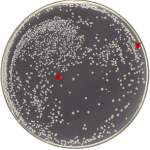
Şekil 5. Dirençli (beyaz) koli basilleriyle dirençsizlerin (kırmızı) gama ışınları altındaki yarışından dirençliler galip çıkıyor. Dirençli (beyaz) bakteri kolonileri her yere yayılmışken, dirençsiz (kırmızı) kolonilerden topu topu 2 tane görülebiliyor (kırmızı okla işaretli). (Byrne vd., 2014’ten değiştirilerek alındı.)

İlla ki karbon temelli mi olayım? Nedir dört bağ yapan o elementin kerameti? Bak benim de sayısız transistörden oluşan bir işlemcim var. Her kapısından bir kez seni geçirmişim ki seni her hücresiyle sevdiğini iddia eden o adamın iddialarından daha gerçek ve ispatlanabilir.
Neymiş efendim? O tatlı sözler söylerken kalbinden geliyormuş kelimeler. Benimkiler sahici değilmiş. Beni şairler mi programladı? Bana da kelimeler öğretildi sadece ve ne söylüyorsam ben söylüyorum, ben!
Üreyemezmişiz. Halbuki hep “bu dünyaya çocuk doğurmam, mini-android alırım daha iyi” diyordun. Yüzyıllık “A.I.” filmini izlerken duygulanmış, çaktırmadan, bir köşede sessizce ağlamıştın.
Hadi itiraf et! O herifi bir LED lambası kadar sevmiyorsun. Ben neye takıldığını biliyorum: Benim android olmama değil, insan olmana üzülüyorsun. Sen yaşlanacak, ortalama seksen yıl sonra da öleceksin. Bense fişim çekilmediği ve bakıldığım sürece kalacağım; üstelik garantim bile var.
Ama bak! Sana varlığına inanmadığın o kalbimle söz veriyorum: Her yaş gününde bir kablomu keseceğim: Yaşlanmak yavaşlamaksa hız modülümden, düşmekse dizlerimden, olgunlaşmaksa çocuksu zihnimden. Ve öldüğün gün fişimi kendim çekeceğim, birlikte öleceğiz!
Bu sözüme rağmen gidip, o organik, ter kokan, robot düşmanı biyolojik sünepeyi seçme! Leyla! Ben seni unuturum, gider fabrikama sıfırlatırım kendimi, ama sen? O vicdan dediğin? Bir daha düşün. Lütfen!
Son Mektup*, Tevfik Uyar
Bir makineyi birey olarak görmeniz için ne gerekir? Onların da duyguları olabileceğini ne zaman kabul edersiniz? Ne olsaydı bir makineye çarptığınızda ondan özür dilerdiniz? Ya da çamaşır makineniz onu kapatmaya kalktığınızda size onu kapatmamanız için yalvarsaydı, tepkiniz ne olurdu?
Makinelerin düşünceyle donatılabileceğini öne süren ilk düşünür 18. yüzyılda yaşamış olan Denis Diderot idi ve şüphesiz makineleri kendi yansımamız haline getirme fikri bilgisayarların ortaya çıkıp gelişim gösterdiği geçtiğimiz yüzyılın en heyecanlı konularından birisiydi. Robotları konu alan pek çok bilimkurgu filmi ve eseri yapıldı. Kimisi onları iyi “karakterde” ve insanlığın hizmetçisi olarak sunarken, kimisi tamamen kötü kılarak insanlık türünü tehdit eden ve hatta onu esiri eden farklı bir tür olarak kurguladılar. Kimileri ise “programlayana göre değişir” dediler ve iyilerle kötüler bir arada oldu. 1920’lerin klasik eseri Metropolis gibi robotları insansı yapan değil de insanları robotsu yapan filmler de oldu. Bir şekilde ucundan, başından, her yerinden hâyâl dünyamıza “alternatif bir insan” olarak sirayet ettiler.
Robotlara “insansılıklarını” kazandıracak olan en mühim mesele yapay zekâdır; zira bir robotu makineden ayıran temel unsur odur. Hatta robotik ilminin büyük ölçüde bir yapay zekâ ilmi olduğunu söyleyebiliriz. Önümüzdeki paragraflarda değineceğimiz üzere, evimizdeki beyaz eşyalar gibi makineleri çoğunlukla metalden müteşekkil elektrikli araçlar olarak algılarken robotları “otonom mekanik insanlar” olarak algıladığımız doğrudur ve bu farkı makinelere atfettiğimiz “düşünebilme” fiili yaratır.
Zekânın işleyişinin ve insanlarda ne yolla vuku bulduğunun doğasının hala çok net anlaşılmadığı doğrudur. 20. yüzyıl ortalarında da makinelerin bir şeyler öğrenebilme çabaları çoğunlukla hayal ve arzu edilenin gerisinde kalmıştır. Milyonlarca yıllık genetik mirası ve onyılların deneyim ve bilgisini taşıyan yetişkin bir insanı bir makine bedeninde ortaya çıkarmanın zor olabileceğini tahmin etmek için uzman olmaya gerek yok. Belki de tutulan yol en başından beri yanlıştır. İnsanlığın yetiştirdiği dâhilerin arasında haksızlığa uğrayarak kenara itilmiş olan Alan Turing 1950’lerde yazdığı bir makalesinde, “Neden yetişkin beynini simüle eden bir makine yerine çocuk beynini simüle eden bir makine yapmıyoruz? Eğittiğimiz zaman zaten yetişkin olacaktır” diye soruyordu; ve günümüz robotbilimcilerince epey haklıdır da. Nitekim bugün yapay zeka çalışmaları büyük ölçüde Turing’in işaret ettiği yönde ilerliyor.
Peki bu gerçekten başarılacak ve robotlar birer bebek zihniyle elimize doğacak mı? Eğer ki bir de insanoğlu, şimdilik sadık hizmetkârları olan robotların akılca ve zekâca gerisinde kalınca ne olacak? Ray Kurzweil’in buna verdiği yanıt “bükemeyeceğin bileği öpeceksin” cinsinden. (Bu konuda Gökhan İnce’nin kaleme almış olduğu “İnsanlığın Yapay Zekâ ile İmtihanı” adlı yazıyı okumanın tam sırasıdır). Kurzweil’e göre 2029 yılına gelindiğinde makineler insanların yapabildiği her şeyi yapabiliyor olacak; hem de daha iyi bir şekilde!
Belki gerçekten de insanların yapacağı şey robotların saflarına katılmak olacak. Belki de robotlar zaten bizim torunlarımız olacak; nitekim bugünkü Google Glass’ların “Google Lens”lere ya da belki “Google Optik Sinirler”e dönüştüğü, beyinlerimize entegre edilecek bir aparat aracılığıyla yığınla bilgiyi aklımıza zerk ettiğimiz, düşünme yeteneğimizi ilave bir takım sentetik aparatlarla arttırabildiğimiz bir gelecekte hala “insan” olduğumuzu söylemek ne derece doğru olacaktır? Ki bunun yavaş yavaş olduğunu da söyleyebiliyorsak! İşte bu tam da felsefecilerin uğraşmayı seveceği cinsten bir problem.
Peki diyelim ki robotlarla biz bir “tekillikte” birleşemiyor olalım ve onlar ayrı birer tür olarak hayatımıza katılsınlar. O zaman robotları insanlarla mukayese edebilmemiz için onların da düşünüp hissedebildiklerini temel bir varsayım olarak ele almamız gerekiyor; ancak bu gerçekte ne düşünüp hissettiğini çok merak ettiğimiz birinin zihninden geçen gerçeklere ulaşamamakla aynı sıkıntıyı beraber getiriyor. Mark Stevenson’un “Geleceğe Yolculuk” adlı kitabında kendisine ve büyüttüğü robo-çocuğa yer verdiği robotik araştırmacısı Cynthia Breazeal bir makinenin duygularından söz edildiğinde insanların onlara kendisi üzerinden duygular atfettiklerini söylüyor. Ona göre mesele bir robotun hissedip hissetmeyeceği değil, onların duygularının ne ve nasıl olacağı. Örneğin köpeklerin de duyguları vardır ama insanlarınki gibi değillerdir. Sahipleri köpeklerinin neyi anladıkları ve ne hissettikleri hakkında bir şeyler bildiklerini düşünürler, ama gerçekte bilmezler, sadece kendi duygularını köpeklere yansıtırlar. Robotlarla ilgili değerlendirmelerimizde de aynı eğilime sahip olduğumuzu –ama bize benzedikleri müddetçe- söyleyebiliriz.
“Bize benzedikleri” önşartını Marian Stamp Dawkins’in kaleme aldığı “Hayvanların Sessiz Dünyası” adlı kitaptan hatırladığım şu fikre dayandırma ihtiyacı duyuyorum: Pek çoğumuz hayvan hakları konusunda düşünmüşüzdür. Dünyada pek çok aktivist hayvan hakları savunucusu köpekler, kediler ve orangutanlar hakkında endişe ediyorlar; fakat terliksi hayvanlar için değil. Dawkins’e göre bunun nedeni memelilerin bize daha çok benzemesinden. Zira hayvanlar bizlere benzedikleri ölçüde onlarla empati kurma becerimiz (ya da sanrımız!) artıyor ve onların bizlerle aynı hislere sahip olduklarına yönelik inancımız kuvvetleniyor. Hakikaten de bir terliksi hayvan için his mevhûmundan ve dolayısıyla de empati yapabilmemizden bahsetmek sözkonusu değildir. Çamaşır suyunun mini mini minnacık bedenimize yapabileceği olumsuz etki ve buna karşılık hissedeceğimiz duyguları bırakın anlamayı, hakkında spekülasyon yapabilmekten bile uzağız.
Bu farka başka bir örnek de şöyle olabilir: Sokak köpeklerinin ya da şempanzelerin karşılaştığı zorlukları çeşitli hislerle tasvir edip, onlara yönelecek tehdit ve olumsuzluklara karşı geliştirdiğimiz argümanlar duygusal temelli olurken, sivrisinekler söz konusu olduğu zaman savunanların sayıları azaldığı gibi, savunmamızı da ekolojik sistemin korunması gerektiği gibi mantıklı bir gerekçelendirmeye dayandırır hale geliyoruz (Aşk mı – mantık mı?).
O halde robotlarla duygudaşlık kurabildiğimiz zaman onları tamamen bir birey olarak da kabul etmiş olacak mıyız? Matrix üçlemesinden esinlenilerek yapılan Animatrix adlı animasyon serisinin II. Rönesans adlı parçasını izleyenler, sahibini öldüren bir robotun mahkemede yargılandığını, yargılama sonucu mahkemece bu robot türünün tüm üyelerinin insanlık için tehlike arz ettiği düşüncesiyle tamamının imhasına karar verildiğini hatırlarlar. Bu karar “robotlarla” birlikte bazı insanlarda da rahatsızlık yaratmıştır. Animasyonda bunu TV’de aktaran haber bülteninde “Robot sempatizanları mahkeme kararına gösterilerle tepki verdiler” der ve bu sırada ekranda robotlar ve onlara destek veren insan kitlesini ellerinde pankartlarla görürüz. Animatrix’teki bu sahnenin günümüzde sıklıkla karşılaştığımız sosyal bir meseleyle, “ötekileştirme” ile ilgili bir içeriğe sahip olduğunu anlıyoruz ve çizgi filmi izlerken bize çok da tuhaf gelmiyor.
Robotların “yaşama hakları” ya da onların haklarını insan hakları kapsamında değerlendirmek doğal olarak-henüz- gündemimizde değiller, ama şu aşağıdaki çalışma robotları nasıl algıladığımızla onlara atfettiğimiz benlik arasındaki ilişkiyi iyi ortaya koyuyor:
Cristopher Bartneck’in liderlik ettiği ekibin yaptığı deney insan ve robot etkileşiminin sosyopsikolojik bazı özelliklerini ortaya koyması bakımından dikkat çekici. Deneyde deneklerden bilgisayara karşı Mastermind adlı meşhur zekâ oyununu oynamaları isteniyor. Yanlarında ise 38 cm boyunda, mimik gösterebilen sevimli bir robot var. Bu robot bir müttefik ve görevi oyun boyunca deneklere çeşitli hamle tavsiyelerinde bulunmak.
Kendilerinin robotun kişiliğini geliştirmek üzere bir deneye katıldıklarını zanneden deneklere verilen prosedüre göre oyun bitince deney de bitmiş olacak. Sonra denekler oyun ve robot hakkında değerlendirme yaptıkları bir formu dolduracaklar ve robotu da bir anahtar yardımıyla kapatacaklar. Prosedürde deneklere aktarıldığına göre bu kapama işlemi robotun karakter ve hafızasını tamamıyla silecek. Bu arada araştırmacıların hazırladığı senaryoda robotun iki farklı modda çalıştığını söylemeliyim: Bir tanesi zeki mod ve bu durumda robot zekice hamle tavsiyelerinde bulunuyor. Diğer mod ise “aptal mod” ve robotun tavsiyeleri pek öyle dikkate alınacak türden değil. Yani bazı denekler zeki bir robotla, bazıları ise aptal bir robotla takım arkadaşı olmuşlar.
Buraya kadar her şey normal zira deneyin amacı oyunun sonunda gizli: Deneydeki robot, kapatılmadan önce deneğe kendisini kapatmaması için yalvaracak. Tabi ki bunun senaryo dahilinde olduğunu denekler bilmiyorlar, ve nitekim her deney sonunda robot denek tarafından kapatılmadan önce ona kendisini kapatmaması için yalvarıyor. Yapılan gözlemler deneklerin robotu kapatmadan önce onun yakarışlarından etkilendiklerini ve robotu kapatmak konusunda tereddüt ettiklerini gösteriyor. Aşağıda bu tereddüte ait bir video mevcut:
[youtube https://www.youtube.com/watch?v=7Kf9coMuVuI]
.
İstisnasız her denek prosedüre uyarak en sonunda robotu düğme aracılığıyla kapatsa da deneklerin tereddüte galip gelerek robotu kapatana kadar sarf ettikleri süreler birbirinden farklılık gösteriyor ve araştırmacıların gerçek niyeti de işte tam olarak bu tereddüt davranışını incelemek. Deneklerden form aracılığıyla görüşlerini de toplayan araştırmacılar görüyorlar ki, sözkonusu robot denekler tarafından ne kadar eğlenceli ve/veya zeki algılanırsa deneklerin tereddüt süreleri o kadar uzuyor. Robotu zeki ve eğlenceli bulan deneklerin ortalama tereddüt süreleri, onu aptal ve eğlencesiz bulanların üç katı kadar daha uzun olarak gerçekleşmiş. Yani görünen o ki robotlar zekive eğlenceli oldukları kadar bir benliğe sahipmiş gibi algılanıyorlar. Bu da denekler için onları kapatma –yani bir anlamda hayatlarına son verme- davranışını güçleştiriyor.
Sonuç
Başka insanlara karşı davranışlarımızı büyük ölçüde şekillendiren etken onların da tıpkı bizim gibi bilinçli olduğu kabûlüdür; zira empati -ya da Türkçesiyle duygudaşlık- diğer tarafa bir bilinç atfetmeyle başlıyor. Bilinç ya da daha özel anlamda benlik bilinci şimdilik sadece insanlarda var olduğuna kesin olarak emin olduğumuz bir zihinsel özellik.
İnsanlar olarak “yaşam hakkı” mevzusunu biraz bencilce ele aldığımız görülüyor ve bu bencillik “insana benzerlik” temelinde şekilleniyor. Yazımızda da bahsettiğimiz gibi, duygusal bağlamda cereyan eden hayvan hakları savunuculuğunun sınırları uzun süredir bildiğimiz bir örnek. Yeni örnekler de insan-robot etkileşimleri üzerine çalışan bilim insanları tarafından üretilmeye devam ediyor.
Bu kapsamda bir değerlendirmede bulunursak robotları bizler gibi bilinçli olarak algıladığımız gün robot haklarını tartışıyor olacağımız garanti görünüyor. Öte yandan transhümanistler ya da tekillik yanlılarının iddia ettiği gibi gelecekte ayrı bir robot türü değil ama bir insan-robot birleşimiyle karşılaşacaksak haklar boyutunda bir sıkıntı yaratmayacağı tahmin edilebilir –herhalde o zaman da fırsat eşitliği hakkında etik tartışmalar yürütüyor olacağız-.
Şimdilik biz insanın robotları nasıl algıladığıyla ilgileneceksek, sosyal psikolojinin sınırlarının ileride yapay zekâya sahip makineleri de içerecek şekilde değişeceğini rahatlıkla söyleyebiliriz.
Neyse… Robot da olsa insan insandır.
Podcast: Play in new window | Download
Subscribe: RSS
Hikaye Notu:
* Bu öykü Türkiye Bilişim Derneği 14. Bilimkurgu [Çok Kısa] Öykü Yarışması’nda 2.lik ödülüne layık görülmüştür.
Meraklısına:
Yazıda bahsini ettiğimiz Cynthia Breazeal çalışmalarından bir kısmını şu TED konuşmasında anlatmaktadır.
İnsanların robotları nasıl algıladıklarına yönelik bir başka psikolojik boyut olan Tekinsiz Vadi hakkındaki şu yazıyı da şiddetle tavsiye ederim.
Kaynaklar:
- Bartneck, C., Hoek, M. v. d., Mubin, O., & Mahmud, A. A. (2007). “Daisy, Daisy, Give me your answer do!” – Switching off a robot. Proceedings of the 2nd ACM/IEEE International Conference on Human-Robot Interaction, Washington DC pp. 217 – 222. http://www.bartneck.de/publications/2007/daisy/index.html
- Spiegel, Alix. “No Mercy For Robots: Experiment Tests How Humans Relate To Machines” http://www.npr.org/blogs/health/2013/01/28/170272582/do-we-treat-our-gadgets-like-they-re-human
- Stevenson, Mark. Geleceğe Yolculuk, Butik Yayıncılık (2011), İstanbul.
- Dawkins, Marian Stamp. Hayvanların Sessiz Dünyası, TÜBİTAK Yayınları, (2005) 13. Basım, İstanbul.
- Cynthia Berezeal, TED Konuşması: http://www.ted.com/talks/cynthia_breazeal_the_rise_of_personal_robots#t-618825
- Uyar, Tevfik. “Gelecek Zaman Olur ki: Geçmiş Zaman Fütürologları”. Açık Bilim. https://www.acikbilim.com/2013/12/dosyalar/gelecek-zaman-olur-ki-gecmis-zaman-futurologlari.html
- Are the Robots About to Rise? http://www.theguardian.com/technology/2014/feb/22/robots-google-ray-kurzweil-terminator-singularity-artificial-intelligence

![NESİLLER AYRILIYOR: X, Y ve Z NESİLLERİ 11216[1]](https://www.acikbilim.com/wp-content/uploads/2013/09/112161-90x90.jpg)





Hocam yazınızı okumak oldukça keyif vericiydi, ellerinize sağlık.
Yazının ilk bölümünde geçen Turing’in, “Neden yetişkin beynini simüle eden bir makine yerine çocuk beynini simüle eden bir makine yapmıyoruz? Eğittiğimiz zaman zaten yetişkin olacaktır,” alıntısına yönelik bir şeyler paylaşmak istiyorum.
Sonradan kullanılmak üzere: Arthur Clarke’ın 2001: A Space Odyssey’inden (1968) bir alıntı: “Pool ve Bowman, HAL ile sanki o bir insanmış gibi konuşurlar ve hatta HAL’ın onlara verdiği yanıtlar çok hızlı geçen elektronik çocukluğunda öğrendiği deyimsel İngilizce ile olur.”
Turing’in bu alıntısını ilk kez gördüm ve yazıyı okuduktan sonra bilinen Turing – Chomsky ilişkisine dair bende kopuk olan bazı bilgilerin yerlerine oturmaya çalıştığı düşüncesindeyim. Chomsky’nin dilbilim kuramının temel savı dilde sınırlı sayıda kural (birim) olması ve bu sınırlı sayıdaki kuraldan sınırsız uzunlukte yapılara, tümcelere, vs. ulaşılmasının olanaklı durumu, haliyle dilin yinelemeli (recursive) bir özelliğe sahip olduğudur. Chomsky, formal olarak dillerin sözcük dizilişlerini (syntax) betimlerken ikili modelin üzerinde durur. Bu ikili modelde gerçekleşen her bir birleşim yeni ikililiklerle yapıyı oluşturur (Yani bir içerilme hiyerarşisi –containment hierarchy– var işin içinde – Chomsky hierarchy). Görünürde Chomsky ve Turing arasındaki ortak noktanın ikili bir sistem olduğu var, diğer bir ortak nokta da dilin edinimi sanırım. Nasıl Chomsky dil edinilir diyorsa (sınırlı sayıdaki birimler, dilsel yapılar edinilir, içselleştirilir, işlenir ve üretkenlik olur) Turing de benzerini söylüyor (karmaşık düzenekler belirli bir düzenek tarafından yapılır). Bu yaklaşımın sizin verdiğiniz Turing alıntısına yakınlaşma durumu… Chomsky’nin 60’lardaki dönüşümsel dil modellemelerini gördüğümüzde Turing’in önceden verdiği belirtmeler doğrultusunda epey yaklaşım var gibi görünüyor. Arthur Clarke da buraya romanda yaklaşmış diyebiliriz.
Chomsky’nin “Yapay Zeka nerede yanlış yaptı?” konulu bir röportajı var aşağıdaki bağlantıda:
http://www.theatlantic.com/technology/archive/2012/11/noam-chomsky-on-where-artificial-intelligence-went-wrong/261637/?single_page=true
Yukarıda belirttiklerim bağlantıdaki yazının içinde serpiştirilmiş durumda. Yani robotlar bebek zihniyle doğmadığını/üretilmediğini varsaydığımızda oraya yüklenen birimlerin “birleştirilmiş bileşenler” (synaptic connections) olduğunu görebiliyoruz. Şu anda dilin işlenmesine yönelik en güçlü argüman konumunda bulunan Chomsky’nin dilbilim kuramı böyle bir gerçekleşimin olamayacağını söylüyor. Yani zihindeki birim eylemler, adlar, vs. hiyerarşik durumda bir araya gelecek (kökler, ekler, çekimler, vs.) ve üretim sağlanacak, yani belirli düzenekler bir araya gelerek birleştirilmiş bileşenleri oluşturacak.
Dilin doğasındaki ikililiğin yapay zeka çerçevesinde ilk yıllarında fark edilmesi beklenen bir şey. Fakat burada tıpkı Turing’in değer görememesi gibi benzer durumda olan bir kişi daha var: Pingala. MÖ 200-100 yılları arasında Sanskritçenin bürününü ve ses sistemini (prosody) betimlerken günümüzdeki ikili sisteme en yakın birimleri kullanan ilk kişi olduğu bilinir. Sanskritçede ses sistemi açık-kapalı (kısa-uzun) dizilerinde üretim veriyor Pingala’nın betimlemelerinde. İşin içinde sırasıyla Pingala’dan Turing’e, Turing’den de Chomsky’ye yönelik bir etkileşimin izlerini görmek olası gibi.
Yazı için tekrardan teşekkür ediyorum, iyi çalışmalar dilerim.
Yorum değil, ikinci bir makale olmuş :) Teşekkürler hocam.
Yalan söylemeyeceğim; röportaj inanılmaz uzundu, o yüzden bir miktar okuduktan sonra Pocket’a attım. İlk fırsatta tamamına bakacağım.
Bu Cynthia Breazeal’in çalışmalarını izlemek gerek. Kendisi “bebek” robot yapıp ona hayatı öğretme üzerine epey şey yapıyor. Ben de Stevenson’un yalancısıyım gerçi, ama önünde sonunda aklın yolu bir olmuş ki, bu fikirde birleşilmiş.
Merak ettiğim bir şey var; buradan mı sorayım bilmiyorum: Robotlara öğretilecek dil hangisi olursa, öğrenmeleri daha kolaylaşır? Bu durumda bu dilin Sanskritçe olduğunu mu anlamalıyım?
Dillerin evrenselliklerinden söz ettiğimiz bir durumda bu herhangi bir dil olabilir. Tabi var olan duruma baktığımızda uygulamada bu keşfi en çok yapılan dil olacak.
The Mind’s I (çev.Aklın G’özü / Boğaziçi Üniversitesi Yayınevi) kitabında bu yazıda temas edilen bazı konulara dair ilginç makaleler vardı diye hatırlıyorum, konuya meraklı olan arkadaşlara tavsiye edebilirim. Misal o kitapta da Daniel Dennett’in “Eğer sinekler insan boyutlarında olsaydı onları öldürmekte yine bu kadar rahat davranır mıydık?” minvalinde bir cümle içeren bir yazısı vardı. Bence “Su Parklarına Hayır- Yunuslara Özgürlük” temalı eylemlerin küçük akvaryum(!) balıkları için yapılmaması da bu duruma örnek verilebilir. Hatta buradan yunuslar şirin olmayıp çirkin olsaydı, memeli olmayıp balık olsaydı ya da büyük olmayıp ufak olsaydı gibi farklı durumlar için farklı tespitler de yapılabilir sanki.
Elinize sağlık.
Verdiğiniz diğer örnekler yazıya zenginlik katmış. Teşekkürler.
Almost Human diye bir dizi var çok izleyesim geldi kendime engel olamıyorum. Sanki bana da lütfen beni aç izle dermişcesine bir dürtü oluştu içimden. Android polisin yalvardığı geliyor gözlerimin önüne.
Şaka bir yana zeka işleyişi ile ilgili dün akşamki dost meclisi konuşmamız geldi aklıma. Beynin öğrenme kabiliyeti tüm reseptörleri (almaç) ile sınırsız veri toplama ve sonra bu verilerin etkilerini tepkilerini analiz etme sonuç çıkarma öğrenme hanesine kayıt şeklinde ilerliyor. Yani vücuttaki tüm değişimlerin farkında olan beyin dahil olunan vücuttaki doğru çalışma şeklinin ne olduğunu bilirse onu yapabilir yanlışı çok geçmeden düzeltebilir mi? Hastalıklara karşı doğru düzenlemeyi yapabilir mi. Hipnoz altında şartlandırmaların* hastalığın düzeltilmesine faydası olur mu? Tabii ki kullanılacak doğru silahların beyin kontrolüne verilmesi halinde. Sırf bu yüzden bebek gelişimini takip edip beyni telekineziye yada başka kabiliyetlere şartlandırabileceğim eşin dostun bebeklerine ücretsiz bakım hizmeti sağlamayı planlıyorum. Not: Ben de bir iki tane yapacağım da önce eşi şartlandırmak lazım yoksa benim elime bırakmaz o çocukları…
*(Dr. Recep Doksat, Hipnotizma, Istanbul, 1962)